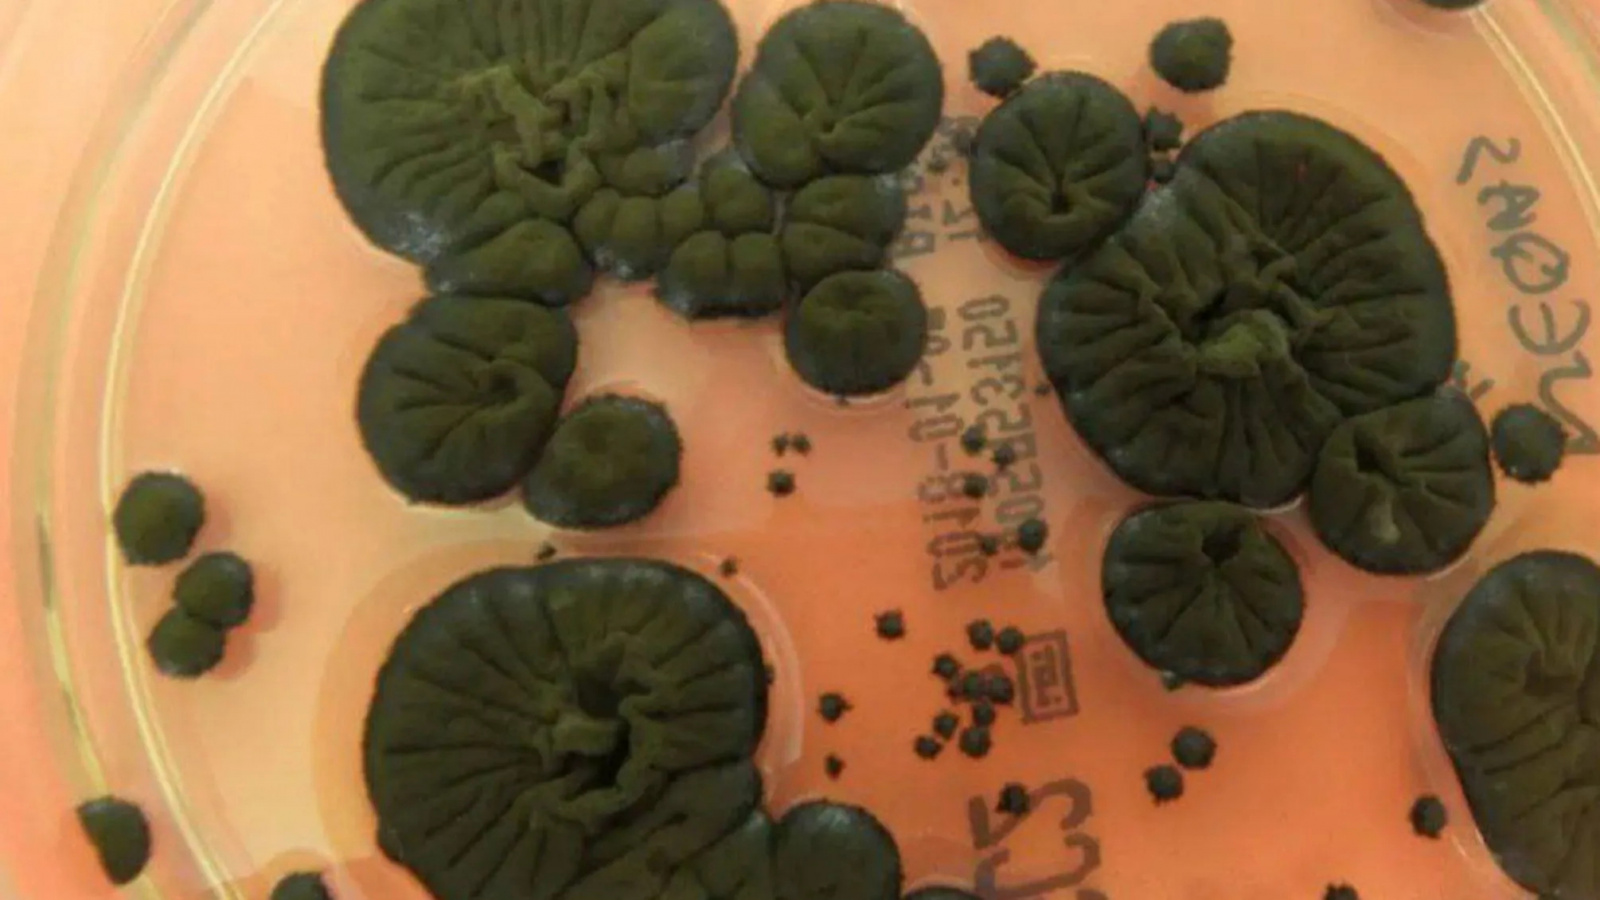

В Чернобыльской зоне на стенах разрушенного энергоблока обнаружили необычный гриб, способный использовать радиацию как источник энергии. Об этом сообщает ScienceAlert.
Редкий организм — черный гриб Cladosporium sphaerospermum — привлек внимание ученых благодаря высокому содержанию меланина. По мнению исследователей, именно этот пигмент позволяет грибку преобразовывать ионизирующее излучение по аналогии с тем, как растения используют солнечный свет для фотосинтеза.
Образцы нашли в местах с экстремально высоким уровнем радиации. Лабораторные тесты показали, что под воздействием излучения гриб не только оставался жизнеспособным, но и ускорял рост. Ученые отмечают: подобная реакция полностью противоположна тому, что происходит с большинством живых организмов.
Необычное явление получило название «радиосинтез». При этом механизмы, лежащие в основе процесса, пока остаются загадкой — исследователи продолжают изучать, как именно Cladosporium sphaerospermum преобразует смертельный фон в энергию для роста.
Новости бегут быстрее, чем вы успеваете читать. Следите за ними в нашем Telegram канале
- На Солнце произошла мощная вспышка X1.9: ученые предупреждают о возможных последствиях
- «Полное безумие»: одна область на Солнце вызывает мощнейшие вспышки два месяца подряд
- Астрономы объявили дату самого яркого звездопада 2025 года
- Активное Солнце возвращается: ждём новые вспышки и гигантские протуберанцы
- От Солнца оторвался протуберанец размером в 80 Земель